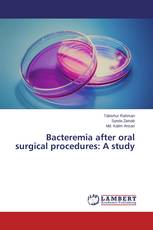
Bacteremia after oral surgical procedures: A study

Bacteremia after oral surgical procedures: A study
Tabishur Rahman, Syeda Zainab, Md. Kalim Ansari - ISBN: 978-3-659-68324-4
Magagement of Macrophomina root rot of mungbean
Use of Trichoderma harzianum and Sisymbrium irio as natural antifungal agents
Laiba Afzal, Arshad Javaid, Amna Shoaib - ISBN: 978-3-659-62229-8
Volatility Analysis and Forecasting Volume Data of DSE
Ahammad Hossain, Ayub Ali, Md. Kamruzzaman - ISBN: 978-3-659-68366-4
Development of mushroom powder and its application in bread
Ali Asghar, . Aamna - ISBN: 978-3-659-16634-1
Hydrological Modeling in Middle Narmada Basin, India using SWAT Model
Sumant Diwakar, Surinder Kaur, Nilanchal Patel - ISBN: 978-3-659-48217-5
Эффективность сельхозорганизаций интегрированного типа
аграрное производство, интеграционный процесс, сельскохозяйственная организация, интенсификация, эффективность
Лидия Головина, Ольга Логачева - ISBN: 978-3-659-67617-8
Репрезентативные системы школьников: содержание, диагностика, развитие
Внутренние способы представления информации как резерв эффективного обучения
Игорь Зуев - ISBN: 978-3-659-64767-3
Challenges in Protection of Copyright due to Technological Innovations
Manzoor Elahi Laskar, Nafisa Laskar - ISBN: 978-3-659-67166-1